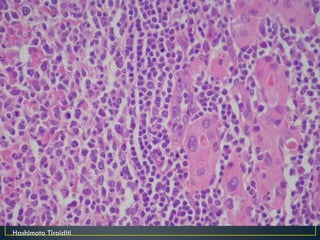
Hashimoto Tiroiditi

More Related Content
PPS
Karaciğer patoloji pratik e4 b2(byramazankaya)2 PPT
Solunum si̇stemi̇ hastaliklari PPTX
PPS
Gastro patoloji pratik e4 b2(byramazankaya)1 PPS
Pankreas ve biliyer sistem patoloji pratik e4 b2(byramazankaya)3 PPTX
PPT
PPT
Amiloidoz (fazlası için www.tipfakultesi.org ) What's hot
PPT
e4b3 patoloji pratik sınavı sunumları | byramazankaya http://www.tipciyiz.biz PPT
PPTX
e3b1 Patoloji by ramazan kaya Tipciyiz.Biz PPT
3)deri patolojisi pratik 2015 PPSX
Parazitoloji pratik-sınavı-e3b1-eutf-tipciyiz-biz-ramazan-kaya PPT
Pankreas ca (fazlası için www.tipfakultesi.org) PPT
Safra kesesi-ve-safra-yollari PPT
PPT
Lenfoid sistem patolojisi (3) PPT
PPT
PPTX
ÖDEMLİ HASTAYA YAKLAŞIM.pptx PPTX
E4 b4 patoloji_pratik-tipciyizbiz-ramazankaya PPT
Kardiyolojide fizik bulgular(fazlası için www.tipfakultesi.org) PDF
Akut kolesistit (fazlası için www.tipfakultesi.org) PPT
PPT
Karaci̇ğer patoloji̇si̇ prati̇ği̇ 2014 2015 PPT
Tiroid (fazlası için www.tipfakultesi.org ) PPTX
PDF
HİPERKALSEMİ VE HİPOKALSEMİYE YAKLAŞIM Viewers also liked
PPS
PPT
PPT
Funda yılmaz pratik cvs 2010 2011 PPTX
4 patoloji pratik e4 b1(byramazankaya) PPT
2a dolaşım pratik 2010 deniz nart PPTX
4 patoloji pratik e4 b1(ramco) PPT
PPT
2b funda yılmaz pratik cvs 2010 2011 PPTX
4 patoloji pratik e4 b1(ramco) PPT
PPS
Similar to Endokrin patoloji pratik e4 b2(byramazankaya)4
PPT
2015 endokrin pratik yeşim ertan PPT
Metaplastik karsinomlar, sarkomlar: Serpil Dizbay Sak PPTX
Duktal-lobüler dışı kanserlerin histopatolojisi: Gülnur Güler PPTX
baş boyun kitlelerine yaklaşımaaa.pptx PDF
Hi̇pofi̇z tümörleri̇ne endokri̇n yaklaşim ve preoperati̇f hazirlik-TARK PPT
Tiroid kanserleri (fazlası için www.tipfakultesi.org ) PPTX
paranasal sinüs tm aproacfffaklaşım.pptx PPTX
paranazal sinüs tümörlerine yaklaşım.pptx PPTX
PPT
Ozel durumlarda radyoloji PPTX
Adrenal bezin hiperfonksiyonları.pptx PPT
Endokrin patoloji pratik e4 b2(byramazankaya)4
- 1.
- 2.
- 3.
- 4.
- 5.
- 6.
- 7.
- 8.
- 9.
- 10.
- 11.
- 12.
- 13.
- 14.
- 15.
- 16.
- 17.
- 18.
- 19.
- 20.
- 21.
- 22.
- 23.
- 24.
- 25.
- 26.
- 27.
- 28.
- 29.
- 30.
- 31.
- 32.
- 33.
- 34.
- 35.
- 36.
- 37.
- 38.
- 39.
- 40.
- 41.
- 42.
- 43.
- 44.
- 45.
- 46.
- 47.
- 48.
- 49.
- 50.
- 51.
- 52.
- 53.
- 54.
- 55.
- 56.
- 57.
- 58.
- 59.
- 60.
- 61.
- 62.
- 63.
- 64.
- 65.
- 66.
- 67.
- 68.
- 69.
- 70.